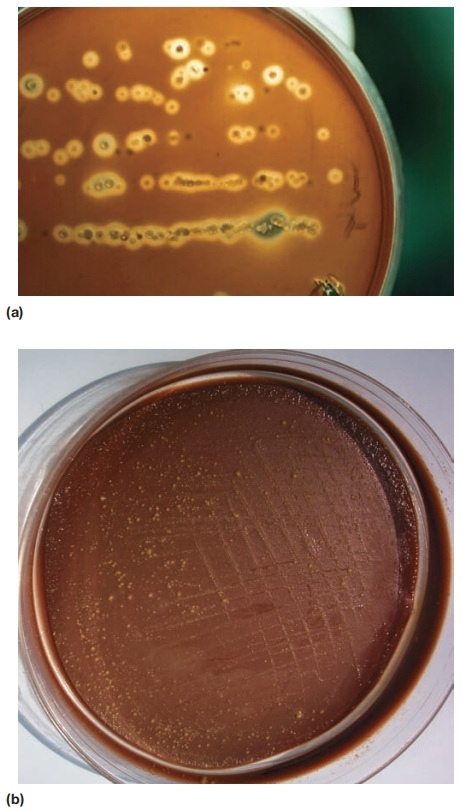

从入门到精通03:微生物纯培养富集与分离
来源:武汉市灰藻生物科技有限公司 浏览量:67 发布时间:2026-01-21 09:28:47
培养基
很多时候,微生物学的研究依赖于,实验室培养和保藏,需要合适的培养基(culture media)。
培养基,是用于培养、运输和储存微生物的固体或液体介质,包含微生物生长所需营养。
专用培养基,对微生物的分离鉴定、抗生素测试等至关重要。
尽管所有微生物都需要能量、碳、氮、磷、硫及多种矿物质来源,但合适的组成取决于要培养的物种,
了解微生物自然栖息地,有助于选择适当培养基,因其营养需求反映自然环境。
培养基基于多种参数分类:化学成分、物理性质和功能。
表1 培养基类型
| 物理性质 | 化学组成 | 功能类型 |
|---|---|---|
| 液体 | 定义(合成) | 支持(通用) |
| 半固体 | 复杂 | 富集 |
| 固体 | 选择性 |
所有化学成分已知的培养基,称为预定义培养基(defined medium)或合成培养基。
可以是液体形式(肉汤)或通过琼脂固化。预定义培养基常用于,培养光能无机自养生物,如蓝细菌和光合原生生物。
这些生物可在相对简单培养基生长,含CO2作为碳源(常添加碳酸钠或碳酸氢钠)、硝酸盐或氨作为氮源、
硫酸盐、磷酸盐和多种矿物质。
表2 定义培养基示例
| BG-11 蓝细菌培养基 成分(g/liter) | 大肠杆菌培养基 成分(g/liter) |
|---|---|
| NaNO3 1.5 K2HPO4·3H2O 0.04 MgSO4·7H2O 0.075 CaCl2·2H2O 0.036 柠檬酸 0.006 柠檬酸铁铵 0.006 EDTA(Na2Mg盐) 0.001 Na2CO3 0.02 微量元素溶液a 1.0 ml/liter 最终pH 7.4 | 葡萄糖 1.0 Na2HPO4 16.4 KH2PO4 1.5 (NH4)2SO4 2.0 MgSO4·7H2O 200.0 mg CaCl2 10.0 mg FeSO4·7H2O 0.5 mg 最终pH 6.8-7.0 |
| a微量元素溶液含H3BO3、MnCl2·4H2O、ZnSO4·7H2O、Na2Mo4·2H2O、CuSO4·5H2O和Co(NO3)2·6H2O | |
许多化能有机异养生物,也可在,以葡萄糖为碳源、铵盐为氮源的预定义培养基中生长。
并非所有定义培养基都简单,也可能包含数十种组分。
定义培养基被广泛应用,因为需要了解实验微生物代谢物质。
复杂培养基(complex media)含某些化学成分未知成分。
这类培养基非常有用,单一复杂培养基可能足够,满足多种不同微生物营养需求。
此外,当特定微生物营养需求未知,无法构建定义培养基时,常需要复杂培养基。
许多营养要求复杂的苛养细菌就属这种情形,甚至可能需要含血液或血清培养基。
复杂培养基含蛋白胨、肉提取物和酵母提取物等未定义成分。
蛋白胨(peptones),是通过部分蛋白水解消化肉类、酪蛋白、豆粕、明胶等蛋白质来源制备,提供碳、能量和氮源。
牛肉提取物(beef extract)和酵母提取物(yeast extract),分别是瘦牛肉和啤酒酵母水提取物。
牛肉提取物含氨基酸、肽、核苷酸、有机酸、维生素和矿物质。
酵母提取物是B族维生素,以及氮和碳化合物极佳来源。
表3 常见复杂培养基
| 营养肉汤 成分(g/liter) | 胰蛋白胨大豆肉汤 | 麦康凯琼脂 |
|---|---|---|
| 牛肉提取物 3 蛋白胨(明胶水解物) 5 | 胰蛋白胨(酪蛋白胰酶消化物) 17 大豆蛋白胨 3 葡萄糖 2.5 氯化钠 5 磷酸氢二钾 2.5 | 胰蛋白酶水解明胶 17.0 酪蛋白胰酶消化物 1.5 动物组织胃蛋白酶消化物 1.5 乳糖 10.0 胆盐 1.5 氯化钠 5.0 中性红 0.03 结晶紫 0.001 琼脂 13.5 |
液体和固化培养基,在微生物学实验室常规使用。
固化培养基,可用于分离不同微生物以建立纯培养,这是证明微生物与疾病关系关键步骤。
定义和复杂培养基,均可通过添加1.0至2.0%琼脂固化,最常用1.5%。
琼脂(agar)是主要由D-半乳糖、3,6-脱水-L-半乳糖和D-葡萄糖醛酸组成硫酸化聚合物。通常从红藻提取。
琼脂作为固化剂有几个优势。其一,在约90°C熔化,但熔化后直到降至约45°C才硬化。
因此在沸水中熔化后,可冷却至人体手部和微生物可耐受温度。
此外,在琼脂培养基上生长微生物可在广泛温度范围培养。
最后,琼脂是优良硬化剂,因为大多数微生物无法降解它。
有时也使用其他固化剂。例如,硅胶用于在无有机物质存在下培养自养细菌,
或通过补充各种有机化合物确定异养细菌碳源。
琼脂作为固化剂发现与纯培养分离
最早培养基是液体,使细菌分离制备纯培养极为困难。
实践中,细菌混合物连续稀释,如果一切顺利,如此分离单个细菌将繁殖形成纯培养。
这种方法繁琐,结果多变,且受污染问题困扰,分离病原菌进展自然缓慢。
发展在固体培养基,获得纯培养,归功于德国细菌学家罗伯特·科赫,及其同事努力。
1881年,科赫发表文章描述使用煮沸土豆,用火焰消毒刀切片培养细菌。
无菌土豆片表面用针尖接种细菌,然后在表面划线使少量单个细胞与其余分离。
切片在钟罩下培养防止空气污染,分离细胞发育成纯菌落。
不幸很多细菌在土豆片上生长不佳。
同时,科赫同事开发肉提取物蛋白胨培养基。
科赫将培养基和明胶混合物,铺在玻璃板上,让其硬化,
以与接种土豆片相同方式接种表面。新固体培养基效果良好,但无法在37°C培养(大多数人细菌病原体最佳温度),
因为明胶会熔化。此外,一些细菌消化明胶。
约一年后,1882年,琼脂首次用作固化剂。它由日本旅馆老板多和良太郎发现。
故事说他倒掉多余海藻汤,次日发现它在寒冷冬夜凝固。
荷兰东印度人已用琼脂制作果冻和果酱。
科赫助手从荷兰熟人处得知琼脂,琼脂固化培养基开发成功,至今仍是微生物学各领域必需品。
功能型培养基
胰蛋白胨大豆肉汤和胰蛋白胨大豆琼脂等,称为通用培养基(general purpose media)或支持性培养基(supportive media),
血液和其他特殊营养物,可添加到通用培养基中,促进苛养微生物生长。
这些特别强化培养基(如血琼脂)称为富集培养基(enriched media)。
富集培养基: (a)人咽喉细菌血琼脂培养。(b)巧克力琼脂,一种用于培养苛养生物如淋病奈瑟菌富集培养基。棕色是加热红细胞并在添加到培养基前裂解结果。因其巧克力棕色而得名。
选择性培养基(selective media)有利于特定微生物生长。
胆盐或碱性复红和结晶紫等染料,通过抑制革兰氏阳性菌生长,有利于革兰氏阴性菌生长;
这些染料对革兰氏阴性生物无影响。远藤琼脂、伊红美蓝琼脂和麦康凯琼脂,是三种广泛用于检测水中和其他地方大肠杆菌及相关细菌培养基。
这些培养基含抑制革兰氏阳性菌生长染料。麦康凯琼脂也含胆盐。
细菌也可通过与它们特异利用营养物一起培养选择。
仅含纤维素作为碳和能源培养基在分离纤维素消化细菌方面非常有效。
选择可能性无穷无尽,有数十种特殊选择性培养基在使用。
表4 选择性和差异性培养基作用机制
| 培养基 | 功能类型 | 作用机制 |
|---|---|---|
| 血琼脂 | 富集和差异性 | 血琼脂支持许多苛养细菌生长。这些细菌可根据产生溶血素能力区分—溶血素是裂解红细胞蛋白质。溶血在菌落周围表现为透明区(β-溶血)或绿色晕圈(α-溶血)(如化脓性链球菌,一种β-溶血链球菌)。 |
| 伊红美蓝(EMB)琼脂 | 选择性和差异性 | 两种染料,伊红Y和亚甲蓝,抑制革兰氏阳性菌生长。它们也与某些革兰氏阴性菌利用乳糖或蔗糖作为碳和能源来源时释放酸性产物反应。产生大量酸性产物革兰氏阴性菌菌落呈绿色金属光泽(如粪便细菌如大肠杆菌)。 |
| 麦康凯(MAC)琼脂 | 选择性和差异性 | MAC中选择性成分是胆盐和结晶紫,抑制革兰氏阳性菌生长。乳糖和中性红(pH指示剂)存在,允许根据利用乳糖作为碳和能源来源时释放产物区分革兰氏阴性菌。释放酸性产物菌落呈红色(如大肠杆菌)。 |
| 甘露醇盐琼脂 | 选择性和差异性 | 7.5% NaCl浓度选择性促进葡萄球菌生长。致病性葡萄球菌可根据利用甘露醇作为碳和能源来源时释放酸性产物区分。酸性产物使pH指示剂(酚红)变黄(如金黄色葡萄球菌)。 |
差异性培养基(differential media),是区分不同微生物群培养基,
允许基于生物特征,初步鉴定微生物。血琼脂既是差异性培养基,也是富集培养基。
它区分溶血性和非溶血性细菌。溶血性细菌(如从咽喉分离许多链球菌和葡萄球菌)
因红细胞破坏在菌落周围产生透明区。麦康凯琼脂既是差异性也是选择性。
因为它含乳糖和中性红染料,发酵乳糖菌落呈粉红至红色,很容易与非发酵菌菌落区分。
纯培养富集与分离
在自然栖息地,微生物通常在复杂混合种群中生长,含多个物种。
这对微生物学家是问题,因为单一类型微生物,在混合培养中无法充分研究。
需要纯培养(pure culture),即来自单一细胞细胞群体,
以表征单个物种。纯培养如此重要,德国细菌学家罗伯特·科赫发展纯培养技术改变了微生物学。
在纯培养技术发展后约20年内,大多数导致主要人类细菌疾病病原体已被分离。
有几种方法制备纯培养,下面回顾几种更常见方法。
涂布平板和划线平板
如果细胞混合物在琼脂表面以相对低密度铺开,每个细胞长成完全独立菌落—
固体培养基上宏观可见生长或微生物簇。因为每个菌落来自单个细胞,每个菌落代表纯培养。
涂布平板(spread plate)是实现此结果简单直接方法。
含约30至300个细胞稀释微生物混合物小体积转移到琼脂平板中心,
用无菌弯玻璃棒均匀铺在表面。分散细胞发育成孤立菌落。
因为菌落数应等于样品中活生物数量,涂布平板可用于计数微生物种群。
纯菌落也可从划线平板获得。


涂布平板技术:
(a)涂布平板制备:(1)将小样品移液至琼脂培养基平板中心。(2)将玻璃涂布器浸入乙醇烧杯。(3)短暂火焰消毒乙醇浸湿涂布器,让其冷却。(4)用消毒涂布器将样品均匀铺在琼脂表面。
(b)涂布平板技术典型结果
微生物混合物用接种环或拭子转移到琼脂平板边缘,然后以几种模式之一在表面划线。
划完第一区后,接种环消毒,第二区接种物从第一区获取。
划第三区遵循类似过程,但接种物来自第二区,本质上是稀释过程。
最终,环上细胞极少,单个细胞在环沿琼脂表面摩擦时掉落。
这些发育成独立菌落。在涂布平板和划线平板技术中,成功分离取决于单个细胞空间分离。

划线平板技术:显示典型划线模式(a)和划线平板示例(b)。注意:此方法仅在步骤1-4后重新消毒划线工具(通常为接种环)时有效。
倾注平板
倾注平板广泛用于原核生物和真菌,可产生单菌落。
将原始样品稀释数次,充分减少微生物数量,以便平板分离时获得独立菌落。
然后将几个稀释样品小体积与冷却至约45°C液体琼脂混合,立即将混合物倒入无菌培养皿。
大多数细菌和真菌不会被短暂暴露于温热琼脂杀死。
琼脂硬化后,每个细胞固定在位置,形成独立菌落。
与涂布平板一样,倾注平板可用于确定种群中细胞数量。计数含30至300个菌落平板。
菌落总数等于样品中能在所用培养基生长活微生物数量。
表面生长菌落也可用于接种新鲜培养基,制备纯培养。

倾注平板技术:原始样品稀释数次,充分稀释种群。然后将最稀释样品与温热琼脂混合,倒入培养皿。孤立细胞长成菌落,可用于建立纯培养。表面菌落呈圆形;亚表面菌落呈透镜状(透镜形)。
纯培养富集与分离
当微生物在样品中数量极少时,制备纯培养较困难。
结合使用平板法与选择性或差异性培养基,富集和分离稀有微生物。
良好例子是,分离降解除草剂2,4-二氯苯氧乙酸(2,4-D)细菌。
含2,4-D作为唯一碳源,及所需氮、磷、硫和矿物质组分液体培养基可获得能代谢2,4-D细菌。
当此培养基接种土壤时,只有能利用2,4-D细菌生长。
培养后,原始培养物样品转移到新鲜选择性培养基烧瓶,进一步富集2,4-D代谢细菌。
几次转移后,将出现混合2,4-D降解细菌种群。
通过将此混合物,在含2,4-D作为唯一碳源琼脂上平板培养,可获得纯培养。
只有能在2,4-D上生长细菌形成可见菌落,可进行传代培养。
这种通用方法用于分离和纯化各种细菌,通过选择特定生理特性。
琼脂表面微生物生长
琼脂表面菌落发育帮助微生物学家鉴定微生物,
因为单个物种常形成特征大小和外观菌落。
当混合种群适当平板培养时,有时可根据整体外观识别所需菌落,用于获得纯培养。

细菌菌落形态 (a)肉眼可见细菌菌落形态变化。菌落总体形状和边缘形状可通过从上往下看菌落顶部确定。菌落隆起性质在从侧面观察平板(持平板与眼睛平齐)时明显。(b)常观察到菌落形态示例。(c)菌落形态随细菌生长培养基显著变化。这些美丽雪花状菌落由枯草芽孢杆菌在营养贫瘠琼脂上形成。当面对不良生长条件时,细菌表现合作行为,结果常是类似于非生命系统中分形图案复杂结构。
细菌菌落微观结构,通过扫描电子显微镜检查。菌落微观结构常如其可见外观一样多变。
在自然界,微生物常在生物膜(biofilms)表面生长,微生物粘液包裹聚集体。
通常菌落边缘,细胞生长最迅速。中心生长慢得多,一些菌落较老中心发生自溶。
这是由于菌落内氧气、营养物和有毒产物梯度造成。
菌落边缘,氧气和营养物丰富,氧气和营养物不易扩散到中心,有毒代谢产物不能快速消除,菌落中心生长减慢或停止。
从菌落图片明显看出,在琼脂等固体表面生长的细菌,可形成相当复杂精细菌落形状。
营养扩散和可用性、细菌趋化性和表面液体存在,似乎都在其中起作用。
参考文献
《Microbiology (Seventh Edition)》 | 微生物学,第七版
相关产品
| 货号 | 名称 | 价格 | 规格 |
|---|---|---|---|
| HZB875586 | 碎肉碳水化合物肉汤培养基 | 350 | 250g/瓶 |
| HZB875648 | 庖肉牛肉粒 | 230 | 100g/瓶 |
| HZB875647 | 氯化血红素 | 60 | 5ml/支(0.1mg/ml)、5支/盒 |
| HZB875646 | 维生素K1 | 50 | 5ml/支(1mg/ml)、5支/盒 |
| HZB875650 | L-半胱氨酸盐酸溶液 | 60 | 1ml/支(0.05g/ml),5支/盒 |
敬请关注灰藻生物,共筑健康未来!
— 武汉市灰藻生物科技有限公司团队敬上
灰藻生物:我们期待着与客户共同成长,共创生命科学的美好未来!
更新日期:2025-01-21
编制人:小藻
审稿人:小藻